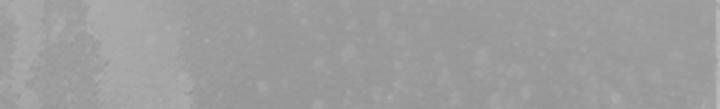
đọc truyện Tạng Phong Hành Chương 221 ảnh 16 tại Thiên Thai Truyện

- Trang chủ
- Theo dõi
- Lịch sử
- Tìm kiếm
-
Thể loại
cmanga HOT thegioisach HOT damconuong HOT sayhentai HOT truyenvn HOT manhwax HOT truyen3q HOT hanul HOT Yuri Garden HOT Adult HOT Ecchi Harem Hentai Manhwa HOT Smut HOT Truyện Tranh 18+ Webtoon Manhua HOT Mature Manga HOT Thiên Thai Ntr Ngực Lớn Milf Đam Mỹ HOT Manhwa 18+ HOT Yuri HOT Yaoi HOT Big Ass Blowjob
- Fanpage
- Group
Đăng xuất
x
-
Trang chủ
-
Theo dõi
-
Lịch sử
-
Tìm kiếm
-
Thể loại
cmanga thegioisach damconuong sayhentai truyenvn manhwax truyen3q hanul Yuri Garden 18+ Adult Ahegao Comedy Comic Drama Ecchi Echi Hài Hước Harem Hentai Hiện Đại Lãng Mạn Manhwa Romance Smut Tình Cảm Truyện Dài Truyện Màu Truyện Tranh Truyện Tranh 18+ Vếu To Webtoon Manhua Mature Manga One Shot Oneshot 18&043; Big Boobs Blowjobs Thiên Thai Cổ Đại Cổ Trang Game Ngôn Tình Trọng Sinh Ntr Ngực Lớn Doujinshi Group Không Che Milf Loạn Luân Mind Break Nữ Sinh Bạo Dâm Giáo Viên Hậu Môn Chơi Hai Lỗ Virgin Hãm Hiếp Lão Già Dâm Loli Ngực Nhỏ Psychological School Life Học Đường Thanh Xuân Vườn Trường Series Housewife Fantasy Boy Love Slice Of Life Phép Thuật Hiện Thực Kịch Tính Boylove 18+ Cao H Đam Mỹ Điên Cuồng - Độc Chiếm - Biến Thái Khẩu Vị Nặng Lạc Miêu Team Manhwa 18+ Truyenvn Bách Hợp Girl Love Girllove Gia Đình Boys' Love 15+ Khác Historical Gangbang Nô Lệ 3d Rape Supernatural Mystery Action Baby Xuyên Sách Tái Sinh Âu Cổ Chuyển Sinh Nhân Thú Nữ Cường Xuyên Không 16+ Horror Thứ 7 Hồi Sinh Ngược Yuri Old Man Josei Sports Shounen Yaoi Seinen Bí Ẩn Mind Control Cousin Sister Nakadashi Big Penis Incest Small Boobs Lolicon Tall Girl Cunnilingus Vanilla X-ray Big Ass Blackmail Full Color Schoolgirl School Uniform Tsundere Fingering Imouto Có Che Condom Stockings Teacher Glasses Catgirls Twintails Shimapan Garter Belts Ponytail Masturbation Che Ít Handjob Breast Sucking Sweating Paizuri Animal Crotch Tattoo Deepthroat Humiliation Business Suit Cosplay Swimsuit Double Penetration Cheating Exhibitionism Sex Toys Anal Idol Dark Skin Hentaivn Femdom Netori Hairy Che Nhiều Miko Drug Slave Osananajimi Kimono Tomboy Bondage Based Game Pregnant Shota Zombie Dirty Old Man Short Hentai Mother Sleeping Trap Rimjob Oral Breastjobs Footjob Futanari Kuudere Bloomers Nurse Ghost 3d Hentai Isekai Nun Twins Bbw Dirty Brother Bbm Artist Cg Monster Elf Pantyhose Y Tá Tracksuit Daughter Doggirl Gothic Lolita Furry Animal Girl Bodysuit Maids Gender Bender Demongirl Monstergirl Demon Elder Sister Yandere Siscon Brocon Devilgirl Bdsm Chikan Body Swap Adventure Tentacles Giả Tưởng Transformation Cưới Trước Yêu Sau Guro Truyện Việt Insect (côn Trùng) Father Kinh Dị Xuyên Không/trọng Sinh Cha Con Anh Chị Em Trẻ Con Shoujo Ai Thứ 6 Bạn Thân Ngây Thơ Shoujo Ác Nữ Hoàng Gia Hài Son Time Stop Foxgirls Devil Ryona Bestiality Chinese Dress Detective Vampire Mizugi Con Gái Nô Angel Apron Sủng Ảnh Động Áo Dài Scat Non-hen Moon Wood I Know The Taste Rimpalla Iburo Đang Cập Nhật Hayeoga Lee Hwa Seong Updating G.ho - Jiho Moon Shadow Butcher Boy Chico Boylove Hành Động Alien & Aladdin Husky Team Yupopo Orishima Taebal Production Yoo Soyoung Con Gái Người Thú Schoolgirl Uniform Truyện Ngắn Neck Pillow Studio Moon Kkyouseung Miyamu Narakuni Black Swan Gorilla Nuwaru Tu Tiên Hệ Thống Ninetys Magazine 19+ 3p Công Sở Sm/bdsm/sub-dom Kissing Prostitution Zilpung Studio Amodsubvn Armpit Tragedy Kim Jong Geon Kkamja Murim Võ Lâm Phiêu Lưu Ob & Ttwook 1vs1 21+ Đẹp Trai Nam Chính Ngoại Tình Thứ 2 3some Time Travel Nhây Đô Thị Tổng Tài Sci-fi Magic Martial Arts Soft Yuri Anh Chị Em Kế Tiểu Thuyết Thứ 5 Đã Full Báo Thù Đạo Sĩ Ngọt Sủng Tình Yêu Thứ 3 Soft Yaoi Trinh Thám Cấu Huyết Mecha Anime Sinh Con Thanh Mai Trúc Mã Vào Game Giai Cấp Quý Tộc Doyeon - Ara Lâm Thanh Kim Seran Thiên Tằm Thổ Đậu Abo Nogizaka Tarou Ô Lí Sửu Sửu Hara Yasuhisa Bạo Lực Huyền Huyễn Tiên Hiệp Novel Châu Âu Trạm Dừng Nữ Phụ Được Nhận Nuôi Bubuchacha Niên Hạ Ngọc Lâu Rô Lai Gulugulu Shounen Ai Mạo Hiểm Nteam Cooking Xuyên Nhanh Vườn Trường Thần Ma Bị Thuốc Live Action Giới Giải Trí Võ Hiệp Mông To Milfs Đeo Kính Mẹ Con Gyaru Vét Máng Lỗ Nhị Hấp Diêm Hentai Cube Cô/dì Nhóm Defloration Không Ntr Succubus Say Xỉn Thủ Dâm Petite Vếu Nhỏ Bisexual Hidden Sex Exhibitionist Vtuber Squirting Huge Ass Leg Lock Pegging Strap-on Horns Females Only Feminization Color Stocking Chastity Belt Bikini Slut Uncensored Ffm Threesome Cheerleader Ponytails Kemonomimi Blowjob Huge Dick Catgirl Huge Boobs Bukkake Lingerie Office Lady Impregnation Collar Piercing Black Skin Crossdressing Maid Small Chest Socks Short Hair Urination No Penetration Black Mail Hentai 3d Insect Garter Belt Monster Girl Big Breasts Lxhentai Sole Female Sole Male Lếu Lều Schoolgirl Outfit Creampie First Time Story Arc Big Dick Comic 18+ Big Vagina Loạn Luân Chị Em Small Breasts Foursome Short Vsuccubus Tragedy Supernatural Romance Ecchi Manga Yuri Slice-of-life All-girl School-life School-life Comedy Rom-com All-girl Doujinshi Loli Shoujo-ai Sci-fi Demon Witch Historical Manhua Horror Animals Fantasy Hint Magical Monster Mystery Tsundere Adventure Post-apocalyptic Drama Psychological Gyaru Seinen Crime Wholesome Oneshot Mecha Military Vampire Violence Big-boobs Harem Nsfw Height-gap Tomboy Sports 4-koma Threesome Full-colour Humorous Triangle Incest Shoujo-ai Age-gap Trauma Nsfw Music Age-gap Vanilla Anthology Insect Maid Twin Isekai Villainess Animals Action Bath Mangaka Paranormal Parody Hint Dark-skin Adult Thriller Mangaka Omegaverse Full-colour Childhood-friends Qrq War Zombie Tentacles Slice-of-life Coming-of-age Anthology Philosophical Magical Cheating Gender-bender Office-lady Manhwa Gore Big-boobs Futanari Rom-com Yandere Drunk 4-koma Ntr Masturbate Bisexual Wholesome Disability Reversal Childhood-friends Gore -
Fanpage
-
Group
- Đăng nhập

Đăng nhập để tham gia cuộc trò chuyện
Đăng nhậpTham gia thảo luận...
Login to reply to this comment
Login to reply to this comment